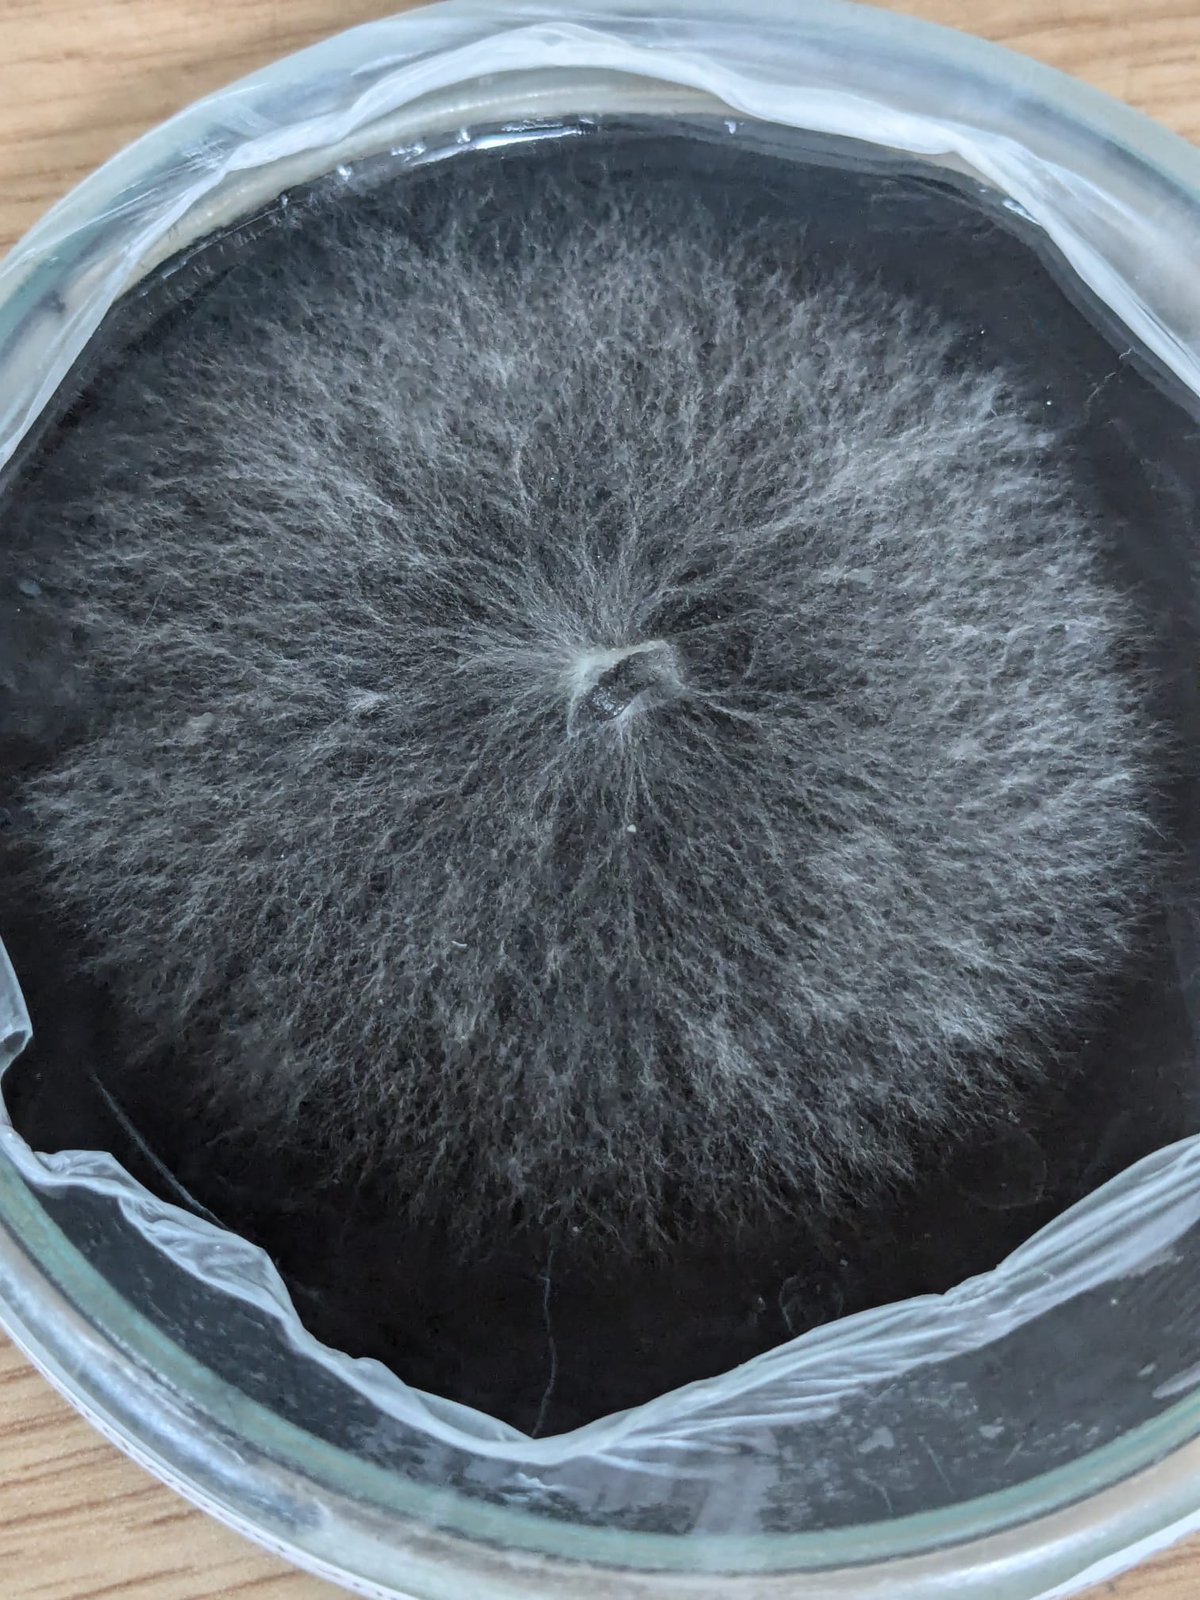

Lion's Mane Powder (3 Month Supply)
75,00 €
100% Lion's Mane Mushroom powder from Mushrooms grown by us in Cobh, Co.Cork. From Agar to Powder every step of the process is done by Us so we can garauntee authenticity and quality.
Quantity : 150g in foil resealable pouch.
-Contains no grain or fillers like maltodextrin just 100% fruiting body.